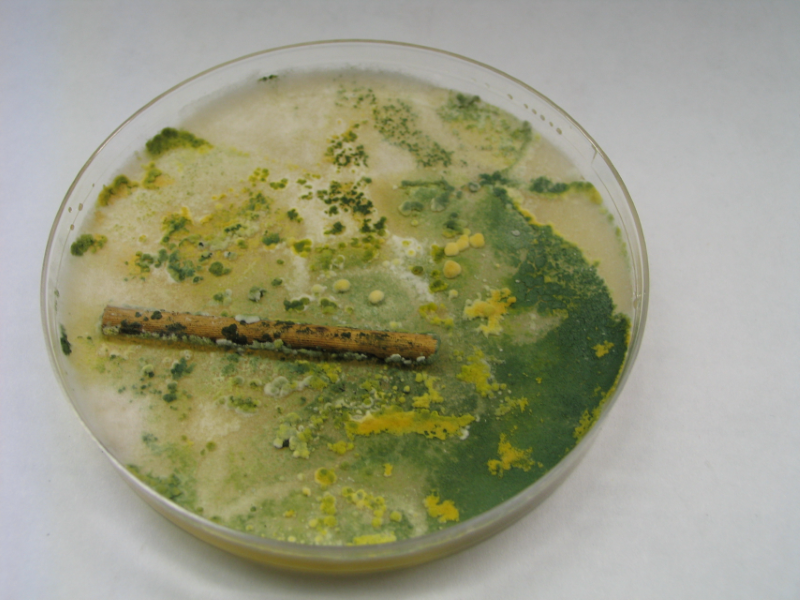
Bild 1: Pilze wachsen aus Sporen auch Algen, Moose und Flechten

Sehr geehrter Interessent,
mit folgenden Fachbegriffen und landesspezifischen Ausdrücken, freuen wir uns, dass Sie uns schnell gefunden haben.
Diese Seite dient dazu, dass Ihre Suche schnell erfolgreich ist...
Weitere ausführliche Informationen, Produktbeschreibungen, Bilder und Preise finden Sie auf unserer Haupt-Info-Seite: Aktiv-Dach
Aktiv-Dach UG
Herbert Neukam
Döbereinerstr. 12
95213 Münchberg
Tel: (09251) 85088-40
Fax: (09251) 85088-41
eMail: info@aktiv-dach.de
Nachfolgend finden Sie REET Fachbegriffe nach Themen geordnet.
Die REET – Dachdecker sind sehr aufgeschlossen und haben REET Erfahrungsaustausch mit Süd Afrika, Schweden, Dänemark, England, Japan usw.
Traufensiebe, Schienen, Gitter Traufengitter, Traufensiebe, Traufenschienen, unteres Dachende, Tropfkante, Dachrinne



hilft dem RETTdach traditionell. Jedes gesunde Dach, vor allem das REETdach braucht eine ausreichende Dachbelüftung; also eine Belüftung an der Traufe und eine Entlüftung am Dachfirst.
REETdach Oberseite, REETdach Oberfläche



REETdach Kehlen sind anfälliger als die Dachfläche.

REETdachgrate müssen sorgfältig befestigt werden, REETdach Grate und REETdach Kehlen sind schwer zu be- und entlüften.
an den Dachseiten
Ortgang, Giebel, Giebelbrett, Giebelblech, Giebelvorsprung, seitlicher Dachabschluss, Giebelkniep, Windbretter

Ortgangbelüftung
Ortgangbrett, Ortgangblech, Ortgangvorsprung, Ortgang, Überstand Dachüberstand, Ortgangkniep, Ortgang Hölzer

muss vorne an der Stirnseite eine Entlüftungsmöglichkeit der darunterliegenden Dachfläche geschaffen werden. Dies kann durch Röhren, Röhrenmatten, oder mit Röhrenpaketen geschafft werden. Mit konventionellen Abluftöffnungen ist eine stirnseitige Abluft nur aufwändig herzustellen.
also, die Dachfläche auf den Gauben, müssen ebenfalls belüftet werden. Dies geschieht durch Traufenlüftungsgitter die sich biegen lassen, also sich an Rundgauben anpassen.
Achtung nicht alle am Markt befindlichen Traufengitter haben den von der REETnorm empfohlenen freien Lüftungsdurchgang von 200 cm²!



Können aus verschiedenen Materialien hergestellt werden: Metall, Ton, Heide, Kupfer REET Beton (ganz früher auf den Inseln) First, Firstblech, Firste, oberer Dachabschluss, Firstziegel, Firstreiter, Firststeine, Firstüberstand, Firstkuppeln, Firsthauben





First aus Kupfer, Ziegelfirst, First mit Tonhauben, Gemörtelter First, Betonfirst, Heidekraut, Heide, Heidekraut, Heide - Plaggen, Heidefirst, Heidekrautfirst, REETfirst, gepflockter Heidefirst, First mit Hängehölzern, REETfirste, REETfirst mit Überstand, REETkappfirst, Kappfirste, Heidefirst mit Hängehölzern
ist ein Naturprodukt.

Das REETdach hat seine Höhen und Tiefen erlebt…
muss/sollte bei Minustemperaturen erfolgen

REET schneiden, REET ernten, REET sortieren, REETanbauländer: Rußland, Litauen, Estland, Lettland, Ungarn, Weißrußland, Rußland, Ukraine, Rumänien, Bulgarien, China usw.
Muss sorgfältig durchgeführt werden

REETtransporte, REETabdeckung, REETcoil, REETcontainer, REETverladung, Haltbares REET, schlechtes REET, gutes REET, teures REET, billiges REET, preisgünstiges REET, geprüftes REET, zertifiziertes REET, REETsorten, REETlagerung, REET abdecken
Wird bestimmt durch schnellen Wasserablauf

Trockenes REET, krummes REET, gerades REET, dickes REET, dünnes REET, stabiles REET, REET putzen, REET säubern, REET sortieren, REET bündeln, REETbunde, stinkendes REET, stickiges REET, vermodertes REET, GlasREET, vergammeltes REET, einwandfreies REET
REET Verschleimung, Verklibberung, Verklipperung, Klipper, Klibber, Schleim, Plack, Plagg, Verplaggung

REET Grünbelag, REET Vermoosung, REET Veralgung, REET Graualge, REET Grünalge, REET Schwarzalge

REET Flechten

REETdach Vermoosung, REETdach Bemoosung, REETdach Entmoosung, REETdach Moos Bildung, Begrünung, REETdachbegrünung, REETdachvergrünung, REETdachverplaggung, REETdachverschleimung, Nasses REET, feuchtes REET, Feuchtigkeit im REETDach ist nicht erwünscht, aber gut messbar.

Kupferpinsel erlauben an Graaten und Kehlen Kupferionen einzusetzen.

Kupfer bzw. Kupferionen verzögern bzw. verhindern Algen, Moose und Flechtenbildung am REETDach. „Kupferpinsel“ (Sturmsicherungsanker mit Kupferquaste) helfen dem REET langfristig.

Beginnt im Labor mit Petrischalen und beschleunigen den Wachstumsprozess deutlich
In kürzester Zeit zeigen sich Ergebnisse, die erst in vielen Monaten bzw. Jahren an REETDach selbst sichtbar werden

Dachreinigung, REETdach abfegen, REETdach abkehren, Reetdach scheren, REETdach flicken, REETdach stopfen, REETdach nachstopfen, REETdach nachbessern, REETdach reparieren, REETdach zustopfen, REETdach aufnehmen, REETdach abreißen, REETdach Entsorgung, REETdach entsorgen, REETdach Lattung, REETdach Traglattung, REETdach Konterlattung, REETdach spritzen, Reith, Ried, mit Chemie behandeln, REETdächer entsorgen, alte REETdächer entsorgen

Die Konzentration der Kupferionen kann über ein ausgeklügeltes schwieriges Messverfahren ermittelt werden.
und deren Wissen, hat nahezu „unsterbliche“ / unverrottbare Produkte geschaffen. Über Sinn und Unsinn chemischer Produkte soll hier nicht diskutiert werden.
ist und bleibt ein chemisch hergestelltes Produkt.

KunstREET wird vor allem in Holland hergestellt. KunstREET hat eine längliche Halm- Form, wie NaturREET. KunstREET ist hohl wie ein natürliches REET. KunstREET hat keine Wachstumsknoten wie Natur Reet. KunstREET hat ein ähnliches Aussehen wie NaturReet. KunstREET kann auch in vorgefertigten Mattenstücken geliefert werden. Künstliches REET hat auch aus der Ferne fast das Aussehen wie Natur REET. Um einen am KunstreetREETdach natürlich aussehenden Dachfirst wird noch wechselweise gearbeitet. Sinn ergibt ein REET – Lüfterfirst aus Kupfer mit Entlüftungszonen. Die Verarbeitung von KunstREET ist ähnlich wie die der alt hergebrachten Verlegung.
ist nach meiner Meinung ein unsinniger Begriff, da alle Naturprodukte und Lebewesen den natürlichen Weg der Verrottung / Verwesung gehen.
Mit dem Begriff REETdachsterben wurde viel Unsinn und Verunsicherung über das tolle Naturprodukt REET erzeugt. Gott sei Dank hat sich der Rummel um den Begriff REETdachsterben wieder gelegt. Der Begriff REETdachstebern wurde wahrscheinlich geprägt, um eine große Verunsicherung um die Langlebigkeit des Naturproduktes REET zu erzeugen. REETdach lebelang hat versucht dies wieder zu relativieren. Reetdach-Lebelang versucht auf natürliche Art und Weise zu helfen.
Kupferfirst, Ziegelfirst, Biberfirst, Pfannenfirst, Betonfirst, Tonfirst, belüfteter First, unbelüfteter First, Firststeine, Firsthohlziegel, Firstklammern, Firstband, Firstbänder, Firstnasen, Firstmulde, halbrunder First, Sechskantfirst, Achtkantfirst, Wulstfirst, Tonnenfirst, Spitzfirst, Firstlatte, Firststreifen, Firstband, Firstrolle, Dachfirst, gemörtelter Dachfirst, Trockenfirst, geklammerter First, Dachfirst verlegen, Dachfirst nachträglich mit Kupfer schützen, Kupferdachfirst, First erneuern, Dachfirst erneuern, Firstziegel erneuern, First- und Gratrolle aus Kupfer, First- und Gratrolle mit 4 Falten, First- und Gratrolle mit 8 Falten, First- und Gratrolle mit 2 Falten, First- und Gratrolle mit Butyl, First- und Gratrolle verkleben, First- und Gratrolle verspannen mit Firstklammern, First- und Gratrolle perforiert, First- und Gratrolle mit Entlüftungsvlies, First- und Gratrolle Verlegung, First- und Gratrolle Video, First- und Gratrolle ablängen
Spezifikationen von Kupferbändern und Kupferrollen sind gleitend Mundarten-Regionen - Ländern - Staaten
Kupfer ist ein toller Werkstoff für das Dach – Kupfer Rollen...
und Kupfer- Platten bzw. Kupfer – Bleche schützen seit Jahrhunderten unser Bauwerke.
Kupfer – Dächer sind sehr langlebig und halten außerdem lästigen Bewuchs, wie ein "lebender Dachreiniger" Algen, Moose und Flechten von der Dachoberfläche fern...
Kupferrollen sind die meistgekauften Kupfer – Rohwaren.
Kupfer in Platten sind häufig bereits zugeschnittene Formate.
Kupferrollen sind in vielen Breiten erhältlich.
Kupferrollen gibt es in vielen Kupfer – Dicken -
Kupferrollen gibt es in vielen Härtegraden - z.B. weich – halbhart - hart
Kupferrollen gibt es in vielen Kupfer – Stärken -
Kupferrollen gibt es in vielen Kupfer – Legierungen mit anderen Metallen z. B. Zink = Bronze
Kupferrollen gibt es in Form von aufgespulten Kupferdraht
Kupferrollen gibt es mit aufgewickelten Röhren
Kupferrollen können mit diversen Butyl-Arten kaschiert sein.
Kupferrollen können mit Butylschichten in verschieden Breiten auf den Kupferrollen - Rückseiten beschichtet sein sein.
Die Butyl-Streifenbreite auf den Kupferrollen ist mit entscheidend über die Haftkraft auf den Untergrund.
Kupferbänder… und Kupferblech ist ein vielseitiger Werkstoff für REETDächer
Kupfer Bänder und Kupfer- Platten bzw. Kupfer – Bleche schützen seit Jahrhunderten unsere Bauwerke.
Kupfer – Dächer sind sehr langlebig und halten außerdem lästigen Bewuchs, wie Algen, Moose und Flechten von der REET Oberfläche fern... ähnlich wie "Dachreiniger"
Kupferbänder sind die am Häufigsten gekauften Kupfer – Halbzeuge.
Kupferbänder in rollenform sind auf handlich zugeschnittene Längen erhältlich.
Kupferband ist in vielen Breiten erhältlich.
Kupferbänder gibt es in vielen, den Verwendungszweck angepassten – Stärken -
Kupferbänder können mit diversen Butylen kaschiert sein.
Die Butylschicht kann in verschieden Breiten auf dem Kupferband aufgetragen sein.
Die Butyl-Streifenbreite auf dem Kupferband ist mit entscheidend über die Haftkraft mit dem Untergrund.
Kupferband gibt es mit strukturierte Oberfläche
Kupferband kann mit Löchern perforiert sein
Kupferband gibt es in kleinwelliger Prägung
Kupferband gibt es in großwelliger Prägung
Kupferbänder werden als Dachreinigungsbänder, Dachentmoosungsbänder, Moosfreibänder Dachreinigungssysteme
Kupferband ist vom Markt nicht mehr wegzudenken